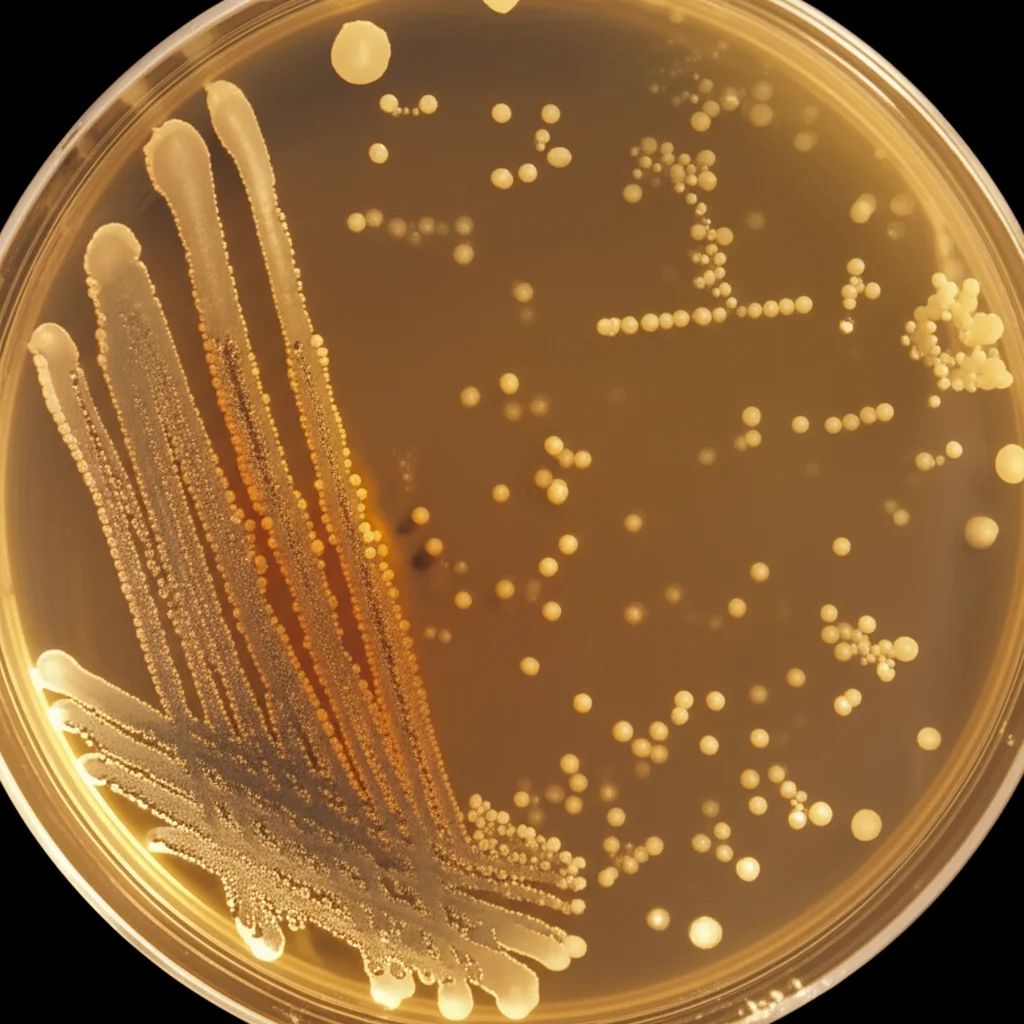
Lenti macro, 85 mm, dettagli elevati, illuminazione controllata, primo piano di diverse colonie batteriche coltivate in una piastra di Petri al microscopio, che rappresenta la complessità del microbiota rinofaringeo influenzato da fattori ambientali.

Aria di Fattoria nel Naso: Come l’Inquinamento Agricolo Cambia i Nostri Microbi (e la Salute Respiratoria)
Ciao a tutti! Avete mai pensato a cosa respiriamo veramente quando siamo in campagna, magari vicino a una fattoria? Certo, l’aria aperta fa bene, ma c’è un lato nascosto che sta emergendo dalla ricerca scientifica, e riguarda dei coinquilini microscopici che abbiamo nel naso: il microbiota nasofaringeo. Sì, proprio lì, nel retro del nostro naso, vive un’intera comunità di batteri, e sembra che l’aria “agricola” possa influenzarla parecchio, soprattutto se si soffre di problemi respiratori come la BPCO (Broncopneumopatia Cronica Ostruttiva).
Recentemente, mi sono imbattuto in uno studio affascinante condotto nei Paesi Bassi, un luogo dove allevamenti intensivi e aree residenziali convivono fianco a fianco. Questo studio ha messo sotto la lente d’ingrandimento proprio il legame tra l’inquinamento atmosferico proveniente dagli allevamenti e il nostro microbiota nasale. E i risultati, lasciatemelo dire, sono piuttosto sorprendenti.
Il Naso: Un Ecosistema Sotto Pressione
Prima di tuffarci nei dettagli, facciamo un passo indietro. Il nostro naso e la gola non sono solo vie di passaggio per l’aria. Sono la prima linea di difesa del nostro sistema respiratorio. Il microbiota che li abita, in particolare quello nasofaringeo, agisce come un “guardiano”, aiutando a mantenere l’equilibrio e a proteggerci da agenti patogeni nocivi. Interagisce costantemente con il nostro sistema immunitario e si adatta ai cambiamenti dell’ambiente esterno. Ma cosa succede quando l’ambiente è costantemente “inquinato” da sostanze provenienti dagli allevamenti, come ammoniaca (NH3), polveri sottili (PM10) ed endotossine (componenti batteriche)?
Lo Studio Olandese: Cosa Abbiamo Scoperto?
I ricercatori hanno coinvolto un bel gruppo di persone: 65 individui con BPCO e 121 controlli sani, tutti non fumatori e residenti in un’area rurale ad alta densità di allevamenti (chiamiamoli gruppo VGO). Per avere un confronto ancora più ampio, hanno incluso anche 116 persone da diverse zone dei Paesi Bassi, rappresentative della popolazione nazionale (gruppo Pienter3). Hanno prelevato campioni dal nasofaringe di queste persone in tre momenti diversi nell’arco di 12 settimane e hanno analizzato il DNA batterico presente (usando la tecnica del sequenziamento del gene 16S rRNA). Contemporaneamente, hanno stimato l’esposizione di ciascun partecipante all’inquinamento agricolo (PM10, endotossine, ammoniaca) presso la propria abitazione, usando modelli di dispersione molto sofisticati.
Allora, cosa è saltato fuori?
- Stabilità Personale: Prima di tutto, abbiamo visto che il microbiota nasale di una persona tende a rimanere abbastanza simile a se stesso nel tempo (nell’arco delle 12 settimane). Le differenze più grandi si notano tra persone diverse, non tanto nello stesso individuo in momenti diversi. Questo ci dice che il nasofaringe è un buon “termometro” per studiare l’impatto di fattori esterni a lungo termine.
- Differenze tra BPCO e Controlli: Qui le cose si fanno interessanti. Nelle persone con BPCO, abbiamo trovato una maggiore abbondanza assoluta di batteri che amano vivere senza ossigeno (anaerobi). Nomi un po’ ostici, ma importanti: Peptoniphilus, Anaerococcus, Finegoldia magna e Prevotella. Allo stesso tempo, batteri “buoni” e comuni come Corynebacterium e Moraxella sembravano essere meno presenti.
- L’Ammoniaca (NH3) è la Star (in Negativo): Tra tutti gli inquinanti agricoli analizzati, l’ammoniaca è emersa come il fattore più influente sulla composizione del microbiota nasale, specialmente nelle persone con BPCO. Spiegava ben il 6,6% della variazione osservata! Concentrazioni più alte di NH3 erano associate a una diminuzione dei batteri commensali “amici” (come Dolosigranulum pigrum e Corynebacterium) e a un aumento degli anaerobi. Sembra quasi che l’ammoniaca crei un ambiente più favorevole per questi batteri potenzialmente problematici.
- Vivere Vicino alle Fattorie: Confrontando i residenti dell’area rurale (VGO) con la popolazione nazionale (Pienter3), abbiamo notato che chi viveva in zone ad alta densità di allevamenti aveva una maggiore diversità microbica nel naso. Più batteri diversi, insomma. Questo potrebbe essere dovuto alla maggiore esposizione a microrganismi presenti nell’aria a causa delle emissioni degli allevamenti. Inoltre, vivere a meno di 500 metri da più di due fattorie era associato a meno Moraxella e più Anaerococcus e Prevotella.
Perché Tutto Questo è Importante?
Questi risultati ci suggeriscono fortemente che l’ambiente in cui viviamo, e in particolare l’aria che respiriamo vicino agli allevamenti, ha un impatto tangibile sul delicato ecosistema batterico del nostro naso. L’ammoniaca, in particolare, sembra giocare un ruolo chiave nel modificare questo equilibrio.
Nelle persone con BPCO, questo squilibrio potrebbe essere ancora più rilevante. La BPCO è già caratterizzata da infiammazione cronica e alterazioni strutturali delle vie aeree. L’aumento di batteri anaerobi, favorito forse dall’ambiente povero di ossigeno tipico delle vie aeree danneggiate e dall’esposizione all’ammoniaca, potrebbe contribuire all’infiammazione o alle riacutizzazioni della malattia. Non sappiamo ancora se questi batteri siano la causa o la conseguenza, ma la loro presenza è un segnale da non sottovalutare.
Pensateci: l’agricoltura è responsabile di una fetta enorme delle emissioni globali di ammoniaca. Questa NH3 non solo può influenzare direttamente il nostro microbiota, ma contribuisce anche alla formazione di particolato fine (PM2.5), noto per i suoi effetti dannosi sulla salute polmonare a lungo termine, inclusi BPCO e cancro ai polmoni.
Cosa Ci Riserva il Futuro?
Questo studio apre nuove strade. Ci fa capire che non possiamo ignorare l’impatto ambientale dell’agricoltura sulla salute respiratoria, e che il microbiota nasale potrebbe essere un mediatore importante in questo processo. C’è ancora molto da scoprire: come esattamente l’ammoniaca e altri inquinanti alterano i batteri? Quali sono le conseguenze a lungo termine di questi cambiamenti? E, soprattutto, possiamo fare qualcosa per mitigare questi effetti?
Serviranno ulteriori ricerche per svelare i meccanismi precisi e per capire se interventi mirati sul microbiota o sulla riduzione dell’esposizione all’inquinamento agricolo possano fare la differenza per la salute respiratoria, specialmente per le persone più vulnerabili come quelle con BPCO.

Insomma, la prossima volta che sentirete l’odore della campagna, ricordatevi che state respirando un’aria complessa, che interagisce con voi a livelli che forse non immaginavate, fin dentro il vostro naso! È un promemoria affascinante di quanto siamo connessi all’ambiente che ci circonda.
Fonte: Springer







